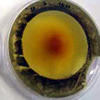
bioplasticos

La Associació de Veterinaris i Higienistes de Catalunya (AVIHC) organiza esta conferencia, que tratará sobre las bases de la genómica y sus posibles aplicaciones en seguridad alimentaria. El evento tendrá lugar en Barcelona el próximo 21 de abril. La asistencia es gratuita con inscripción previa.
La Associació de Veterinaris i Higienistes de Catalunya (AVIHC) organiza esta conferencia, que tratará sobre las bases de la genómica y sus posibles aplicaciones en seguridad alimentaria. El evento tendrá lugar en Barcelona el próximo 21 de abril. La asistencia es gratuita con inscripción previa.

 Las enfermedades transmitidas por los alimentos (ETA) constituyen una causa importante de mortalidad y morbilidad en todo el mundo. Por primera vez, la OMS ha realizado un estudio que aporta las primeras estimaciones mundiales de la incidencia y mortalidad de estas enfermedades, asi como su carga de morbilidad en términos de años de vida ajustados en función de la discapacidad.
Las enfermedades transmitidas por los alimentos (ETA) constituyen una causa importante de mortalidad y morbilidad en todo el mundo. Por primera vez, la OMS ha realizado un estudio que aporta las primeras estimaciones mundiales de la incidencia y mortalidad de estas enfermedades, asi como su carga de morbilidad en términos de años de vida ajustados en función de la discapacidad. La incorporación de agentes biocidas naturales en bioplásticos, hechos a base de gluten de trigo, abre nuevas vias al desarrollo de una industria sostenible del envasado de alimentos. Investigadores de la Universidad de Huelva han desarrollado materiales biodegradables que pueden alargar la vida útil de los alimentos al reducir la proliferación de hongos y bacterias.
La incorporación de agentes biocidas naturales en bioplásticos, hechos a base de gluten de trigo, abre nuevas vias al desarrollo de una industria sostenible del envasado de alimentos. Investigadores de la Universidad de Huelva han desarrollado materiales biodegradables que pueden alargar la vida útil de los alimentos al reducir la proliferación de hongos y bacterias. El Centro Nacional de Epidemiología ha publicado la actualización (septiembre de 2015) de los datos recogidos en la vigilancia de las Enfermedades de Declaración Obligatoria (EDO) en España durante 2014. Entre las enfermedades asociadas al consumo de alimentos, la campilobacteriosis fué la primera causa de gastroenteritis bacteriana notificada. Las tasas más altas de legionelosis se dieron en Catalunya y entre las enfermedades de transmisión vectorial destacan tres casos de transmisión local de malaria.
El Centro Nacional de Epidemiología ha publicado la actualización (septiembre de 2015) de los datos recogidos en la vigilancia de las Enfermedades de Declaración Obligatoria (EDO) en España durante 2014. Entre las enfermedades asociadas al consumo de alimentos, la campilobacteriosis fué la primera causa de gastroenteritis bacteriana notificada. Las tasas más altas de legionelosis se dieron en Catalunya y entre las enfermedades de transmisión vectorial destacan tres casos de transmisión local de malaria. En preparación para el nuevo Documento Guía del GFSI versión 7, que pedirá la implementación de una herramienta de auditoría sin previo aviso dentro de los programas de seguridad alimentaria, el sistema de certificación IFS ha creado el protocolo de auditoría IFS Food. El documento será una parte integral de la actual versión IFS Food 6 y describe el protocolo para realizar auditorías sin anunciar.
En preparación para el nuevo Documento Guía del GFSI versión 7, que pedirá la implementación de una herramienta de auditoría sin previo aviso dentro de los programas de seguridad alimentaria, el sistema de certificación IFS ha creado el protocolo de auditoría IFS Food. El documento será una parte integral de la actual versión IFS Food 6 y describe el protocolo para realizar auditorías sin anunciar. La apicultura en EEUU tiene malas notícias. En ambas costas del pais, se han detectado abejas melíferas parasitadas por la diminuta mosca Apocephalus borealis, que introduce sus huevos en ellas, provocándoles comportamientos extraños, como movimientos erráticos o abandonar la colmena de noche, y finalmente la muerte.
La apicultura en EEUU tiene malas notícias. En ambas costas del pais, se han detectado abejas melíferas parasitadas por la diminuta mosca Apocephalus borealis, que introduce sus huevos en ellas, provocándoles comportamientos extraños, como movimientos erráticos o abandonar la colmena de noche, y finalmente la muerte. La globalización del comercio de alimentos ha dado lugar a cadenas de suministro muy complejas y dispersas, en las que, para que un producto llegue de la granja a la mesa, puede llegar a estar implicada una red de más de 100 empresas. Si algo no funciona correctamente en un punto de esta red, la calidad, seguridad y sostenibilidad del producto final puede verse comprometida y con ello también la confianza del consumidor.
La globalización del comercio de alimentos ha dado lugar a cadenas de suministro muy complejas y dispersas, en las que, para que un producto llegue de la granja a la mesa, puede llegar a estar implicada una red de más de 100 empresas. Si algo no funciona correctamente en un punto de esta red, la calidad, seguridad y sostenibilidad del producto final puede verse comprometida y con ello también la confianza del consumidor. El sector agroalimentario es fundamental para la economía europea y española. Las nuevas tendencias, como cambios en los hábitos de consumo, una legislación más restrictiva, la innovación tecnológica o la preocupación por la sostenibilidad, influyen en las demandas de ocupación en el sector, que se decantan hacia los profesionales relacionados con la calidad y seguridad alimentaria, así como con la innovación tecnológica para incrementar la competitividad.
El sector agroalimentario es fundamental para la economía europea y española. Las nuevas tendencias, como cambios en los hábitos de consumo, una legislación más restrictiva, la innovación tecnológica o la preocupación por la sostenibilidad, influyen en las demandas de ocupación en el sector, que se decantan hacia los profesionales relacionados con la calidad y seguridad alimentaria, así como con la innovación tecnológica para incrementar la competitividad. “Food Defense. Biovigilancia alimentaria” es un curso que se imparte en modalidad MOOC (massive online open course), gratuito y abierto a cualquier persona interesada en las estrategias de vigilancia y protección del consumidor frente a las amenazas de contaminación intencionada de los alimentos, a lo largo de toda la cadena alimentaria. Está organizado por BTC Centro de Estudios Superiores, centro vinculado a la Universidad de Vic.
“Food Defense. Biovigilancia alimentaria” es un curso que se imparte en modalidad MOOC (massive online open course), gratuito y abierto a cualquier persona interesada en las estrategias de vigilancia y protección del consumidor frente a las amenazas de contaminación intencionada de los alimentos, a lo largo de toda la cadena alimentaria. Está organizado por BTC Centro de Estudios Superiores, centro vinculado a la Universidad de Vic.